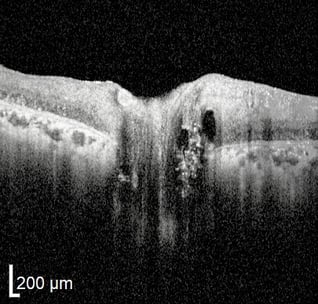
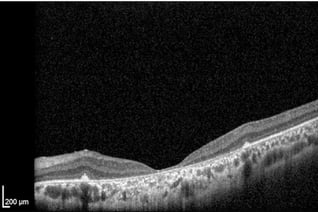

Nicht-invasiv und kontaktlos
Kein chirurgischer Eingriff und nichts berührt das Auge
Schnell und praktisch
Dauert nur wenige Minuten, erfordert keine Pupillenerweiterung
Angenehm und schmerzlos
Verwendet unsichtbares Licht und erzeugt keinen Schmerz
Kein chirurgischer Eingriff und nichts berührt das Auge
Dauert nur wenige Minuten, erfordert keine Pupillenerweiterung
Verwendet unsichtbares Licht und erzeugt keinen Schmerz
Eignet sich auch für sehbehinderte und pädiatrische Patienten, liefert detaillierte und valide Daten
Misst genau und bei einer neuerlichen Untersuchung kann die gleiche Position gescannt werden
Kein subjektives Feedback notwendig, stellt den gegenwärtigen Standard in Ophthalmologie dar
Bevor es die OCT-Technologie gab, wurden Erkrankungen der Netzhaut nur klinisch diagnostiziert. Durch die Querschnittsdarstellungen wurden äußerst wichtige Einblicke in die Pathogenese okularer Erkrankungen ermöglicht, indem entschlüsselt wurde, welche spezifischen Schichten involviert sind, und der Krankheitsprozess besser sichtbar gemacht wurde.
Klinische Studien haben den Nutzen und die Durchführbarkeit der OCT bei Augenerkrankungen wie dem Glaukom, der Retinitis pigmentosa, der Makuladegeneration, der Sehnervenentzündung, Drusen unter Netzhaut und Makula, diabetischer Retinopathie, Makulaödemen, epiretinalen Membranen und Aderhautmelanomen gezeigt.
Bei OCT-Scans sitzt der/die Patient/-in aufrecht, legt das Kinn auf eine Kinnstütze und die Stirn an eine Stirnstütze an. Im Unterschied zum Ultraschall kann bei einer OCT die Luft als Medium anstelle eines Gels verwendet werden. Diese Form der Bildgebung ist kontaktfrei, nicht-invasiv und dauert nur ein paar Minuten. Ein harmloser und unsichtbarer Laserstahl scannt die Netzhaut und den Sehnervenkopf, ohne Schmerzen zu erzeugen. Das Sehvermögen bleibt unbeeinträchtigt und es ist keine medikamentöse Pupillenvergrößerung erforderlich. Die Daten werden von einem Computersystem berechnet und analysiert. Die neuen Aufzeichnungen und Messungen werden automatisch gespeichert und mit früheren Scans verglichen, um mögliche Veränderungen beurteilen zu können. Sogar die geringsten Wertdiskrepanzen bei Retina und Sehnervenkopf werden identifiziert. Der Verlauf der Progredienz wird grafisch aufgezeichnet, damit die im Laufe der Zeit stattfindenden Veränderungen ganz einfach visualisiert werden können.
Obwohl die Diagnose und Interpretation mittels OCT einen vertrauten Umgang mit dem Gerät sowie eine gewisse Erfahrung und eine Ausbildung voraussetzt, können auch „Amateure“ einige grundlegende Prinzipien nutzen, um zu einer elementaren Interpretation zu gelangen.
Je nach Typ des verwendeten OCT-Geräts kann die Analyse der Scans deutlich anzeigen, ob die Dickenmessung der retinalen Nervenfaserschicht (RNFL), der Ganglienzellenschicht (GCL) oder der Makula auf eine normale, abnormal dünne oder abnormal dicke Schicht hindeutet. Es können auch Farbindikatoren verwendet werden, um die relative Stärke eines Bereichs oder einer Schicht im Vergleich zu jenen bei einer gleichaltrigen Kontrollgruppe darzustellen. Auf die Farbenlegende muss genau geachtet werden, denn die Farbskalen können unterschiedlich (und sogar komplett umgekehrt) sein, je nachdem, welches okulare Gebilde man betrachtet.
Im Allgemeinen weist ein gesundes hinteres Segment des Auges keine klinischen oder OCT-Anomalien auf. Die außergewöhnliche Empfindlichkeit des OCT ermöglicht die Darstellung einzelner okularer Strukturen wie des Sehnervs, des Sehnervenkopfes, der retinalen Nervenfaserschicht (RNFL) und der Axonen der retinalen Ganglienzellen.
Bei einer OCT wird ein großer leerer Fleck sichtbar, wo die Axonen das Auge verlassen und kein Ödem auf der Oberfläche der Ränder beobachtet wird. Der Glaskörper erscheint dunkel und durchsichtig, während die innere Grenzmembran und die retinale Nervenfaserschicht stark reflektieren. Die RNFL ist in Richtung der Nase dicker als schläfenwärts, entsprechend dem makulapapillären Bündel.
Die Schichten der Retina sind gut zu unterscheiden, fugenlos (ohne Bruchstellen) und ebenmäßig, während eine kleine Grube in der Kontur bei der Fovea zu erkennen ist. Der hintere kortikale Glaskörper kann leicht an der Makula angeheftet sein oder über der Makula schwimmen.
Die innere und die äußere Körnerschicht sowie die Ganglienzellenschicht reflektieren nur wenig. Die äußere Grenzmembran, die Photorezeptorenschicht und das retinale Pigmentepithel sind hyper-reflektierend. Hinter diesen Schichten befindet sich die weniger reflektierende Aderhaut.

Im Laufe des vergangenen Jahrzehnts ist die OCT, zusammen mit der Perimetrie (Gesichtsfeldmessung), zum Pflegestandard bei der Diagnose und dem Management des Glaukoms geworden. Der stärkste Hinweis auf ein Glaukom ist die fortschreitende Abnahme der Schichtdicke (Schwund) der retinalen Nervenfaserschicht (RNFL) entlang des makulapapillären Bündels über einen bestimmten Zeitraum hinweg. Strukturelle Veränderungen des Nervenfaserkopfes (ONH) in Form einer Exkavation oder Aushöhlung lassen sich anhand der OCT quantifizieren. Auch eine Atrophie (Gewebeschwund) der retinalen Ganglienzellenschicht (GCL) und die Gesamtstärke der Makula sind messbar.

Üblicherweise verursacht eine ischämische Beschädigung des Sehnervs eine mäßige oder starke Schwellung des ONH aufgrund von Sauerstoffmangel. Die Behandlung mit Steroiden ist immer noch umstritten, da noch kein Nutzen nachgewiesen werden konnte. Für gewöhnlich klingt diese Schwellung 8-12 Monate nach dem Eintreten von NAION ab, jedoch ohne Wiederherstellung der Sehkraft. Bei einer chronischen NAION zeigt sich der Schwund der RNFL und GCL. Die OCT-Angiographie ist ein besonders nützliches Gerät für die Diagnose von NAION, da es in der Lage ist, eine reduzierte Kapillardichte sowie die Attenuierung ausgedehnter Blutgefäße darzustellen.

Leberscher hereditäre Optikusneuropathie: Bei der LHON tritt die primäre Schädigung auf der Ebene der retinalen Ganglienzellen auf, sekundär begleitet vom Sehnerv. Die OCT erfüllt eine Schlüsselrolle bei der Diagnose und der Ermittlung des Stadiums der LHON, da die OCT-Muster sich je nach Stadium sehr stark unterscheiden. Bei frühen oder akuten Schüben der LHON kann die RNFL aufgrund eines axonalen Ödems eine Zunahme aufweisen. Im Allgemeinen zeigt sich bei einer chronischen LHON primär ein temporaler Schwund der RNFL und ein sehr starker Rückgang der GCL aufgrund der progredienten Atrophie.

Der Sehnerv neigt dazu, anfällig für systemische Autoimmunentzündungen zu sein. Klinische OCT-Ergebnisse zeigen, dass der temporale Aspekt der RNFL bei einer optischen Neuritis am stärksten betroffen ist, womit nicht nur lokale pathologische Charakteristika wiedergespiegelt werden, sondern auch axonale Degenerationsprozesse. Makula-Scans lassen einen deutlichen GCL-Schwund erkennen, der durch Zellschäden und eine anschließende Atrophie entsteht. Bei einer chronischen Sehnervenentzündung sind ein paar Monate nach Ausbruch deutlich dünnere RNFL zu erkennen. Ähnlich wie bei anderen Erkrankungen kann bei akuten Schüben die Schwellung des ONH eine außergewöhnliche Verdickung der RNFL hervorrufen.

Bei der Sehnerv-Hypoplasie liefert die OCT genaue Messungen der verkleinerten Sehnervenscheibe, die bei einer medikamentösen Fundusuntersuchung festgestellt werden kann. Hypoplastische Sehnervenscheiben haben eine verringerte horizontale Ausdehnung, eine geringere Vertiefung und eine dünne peripapillare RNFL. Eine Hypoplasie der Fovea (Sehgrube) lässt sich als verringerte Makulastärke, verringerte Dicke der GCL und RNFL-Schwund erkennen.

Die OCT hat sich bewährt bei der Unterscheidung von ONH-Ödemen und tiefsitzenden Drusen. Während bei einem Ödem Veränderungen bei der Schichtstärke der RNFL und GCL vorliegen, sind diese Lagen bei Drusen nicht betroffen. Bei einem Ödem kann der anteriore ONH eine abnormale Schwellung der RNFL aufweisen, während der hintere ONH eine glatte Kontur hat. Bei einer kleinen oder mäßig großen tiefsitzenden Drusenpapille ist der vordere ONH jedoch meist nicht betroffen, während der hintere ONH „Dellen“ aufweist, die tiefsitzende Drusenpapillen anzeigen. In schweren Fällen von Drusenpapillen kann eine RNFL-Atrophie sowie ein geringer Sehverlust eintreten.

Schicht der retinalen Ganglienzellen (RGC) basierend auf der Farbzuordnung in Mikrometern (rot=dick, blau=dünn)
Eine glaukomatöse Neuropathie im Frühstadium, wie belegt durch den leichten RGC-Schwund
Fortgeschrittenes Glaukom

Fortgeschrittenes Glaukom mit starkem unterem RGC-Abbau. Auch eine Aushöhlung des ONH ist zu erkennen.
Schweres Glaukom

Starker und diffuser RGC-Schwund. Abnahme der Schichtstärke oben und schläfenwärts ausgeprägter.

Optikusneuropathie. Diffuser und schwerer RGC-Schwund der Makula mit komplettem Verlust in der Fovea.
Lebersche Optikusatrophie

Diffuser, mäßiger zentraler und kompletter fovealer Verlust der RGC aufgrund der Leberschen hereditären Neuropathie.
Traumatische Optikusneuropathie

Schwerer und diffuser makularer RGC-Schwund mit kleinen intakten RGC-Inseln, verursacht durch ein Trauma.
Ischämische Optikusneuropathie
.jpeg?width=200&name=Importe%20-%201%20von%201%20(2).jpeg)
Optikusneuropathie. Fast kompletter Verlust der RGC der Makula aufgrund ischämischer Nervenschäden.
Gesunde Sehnervenpapille

Normale Stärke der retinale Nervenfasern neben dem ONH (Lage zwischen roten und blauen Linien).
Fortgeschrittenes Glaukom

Schwere RNFL-Atrophie aufgrund eines fortgeschrittenen Glaukoms (glaukomatöse Optikusneuropathie).
Lebersche Optikusneuropathie

RNFL-Schwund schläfenwärts bei Leberscher hereditärer Optikusneuropathie.
Traumatische Optikusneuropathie

Endstadium (fast abgeschlossen) der RNFL-Atrophie aufgrund einer traumatischen Optikusneuropathie.
ONH
Glaukom
.jpeg?width=318&name=Importe%20-%201%20von%201%20(6).jpeg)
Typisches Muster einer glaukomatösen Exkavation der Sehnervenpapille.
NAION im fortges. Stadium
.jpeg?width=318&name=Importe%20-%201%20von%201%20(5).jpeg)
Starke Atrophie des Sehnervs durch eine ischämische Optikusneuropathie.
NAION Sehnervenpapille

Ödem auf RNFL und Papille des Kopfs bei intrakranieller Hypertension.
Tieferliegende ONH-Drusen. Anfangsstadium. Pseudopapillenödem.

Die RP ist eine progrediente retinale Dystrophie, die in der peripheren Netzhaut auftritt, bevor sie sich zur Mitte hin weiter ausbreitet. Durch die OCT werden der Verlust der Photorezeptorenschicht PIL (engl. photoreceptor integrity line) der gesamten Netzhaut sowie der Schwund der Aderhaut sichtbar. In der Makula ist sowohl der Schwund als auch die Verdickung rund um die Fovea zu beobachten, und zystische Makulaveränderungen sind festzustellen.

Bei der Zapfen-Stäbchen-Dystrophie sind Anomalien der PIL insbesondere am äußeren Segment der Photorezeptorenschicht zu beobachten. Davon betroffen ist vor allem die Fovea (ein Teil der zentralen Retina zuständig für das schärfste Sehen). Zudem kann die OCT-Autofluoreszenz einen hyperfluoreszenten perifovealen Ring anzeigen, der aufgrund einer Photorezeptoren-Disorganisation und der Veränderung/Atrophie des Pigmentepithels (RPE) eintritt. Innerhalb des RPE kann vermehrt Lipofuszin zu erkennen sein.

Makuladrusen sind das Kennzeichen der altersbedingten Makuladegeneration (AMD). Klinisch erscheinen Drusen als gelbe oder weiße Ablagerungen auf der Retina. Mit der OCT lassen Drusen sich als fokale Ablagerungen in der äußeren Netzhaut, zwischen der basalen Lamina des retinalen Pigmentepithels und der inneren kollagenen Schicht der Bruch‘schen Membran beobachten. Bei einer AMD im frühen oder mittleren Stadium ist normalerweise kein Schwund der Aderhaut zu beobachten. Bei fortgeschrittener AMD jedoch ist mitunter auch ein Schwund der Aderhaut festzustellen. Bei fortgeschrittener AMD werden auch andere retinale Anomalien durch das OCT sichtbar.

Atrophie des retinalen Pigmentepithels (RPE): Bei einer RPE-Atrophie kann man eine Pigmentmigration beobachten, bei der sich an einigen Stellen das RPE Material ansammelt, während es an anderen Stellen fehlt. Das RPE kann an Stellen mit Materialansammlung dicker werden und aufgrund einer Atrophie an andere Stelle dünner. Solche Veränderungen führen zu einer ungleichmäßigen Morphologie des RPE. Das RPE kann auch porös werden, was an Lücken oder Löchern in den Lagen selbst zu erkennen ist. Weniger oft kommt vor, dass eine neovaskuläre Membran der Aderhaut sich bildet und das RPE nach vorne schiebt.
Gesunde Netzhaut

Gleichmäßige, glatte Schichten. Dickere RNFL rechts konsistent mit dem zur Nase hin gelegenen Papillomakulären Bündel.
RP im Frühstadium

Gleichmäßige, glatte Schichten. Dickere RNFL rechts konsistent mit dem zur Nase hin gelegenen Papillomakulären Bündel.
Fortgeschrittenen RP

Gleichmäßige, glatte Schichten. Dickere RNFL rechts konsistent mit dem zur Nase hin gelegenen Papillomakulären Bündel
RP und RPE-Atrophie

Gleichmäßige, glatte Schichten. Dickere RNFL rechts konsistent mit dem zur Nase hin gelegenen Papillomakulären Bündel
Zapfen-Stäbchen-Dystrophie

Fortgeschrittenes Stadium mit Integritätsverlust bei Zapfen und Zelltod. Diffuse RPE-Atrophie. Allgemeiner Netzhautschwund.
Zapfen-Stäbchen-Dystrophie

Anomale Fovea-Kontur aufgrund allgemeiner Retina- und Fovea-Atrophie. RPE fast vollständig verloren.
Morbus Stargardt
Morbus Stargardt. Starker Schwund der Photorezeptoren. Fast vollständiger RPE-Verlust.
*RP - Retinitis Pigmentosa
Als meine Verlobte kurz nach unserer Verlobung einen Großteil ihres Sehvermögens verlor, erklärten uns die Ärzte im Vereinigten Königreich, dass keine Hoffnung bestünde, dass Alex nach ihrer Sehnerventzündung ihre Sehkraft wieder zurückerhält. Wir waren am Boden zerstört und wollten schon aufgeben. Wir haben zwei Wochen in Berlin verbracht und die hervorragende, fürsorgliche Pflege der Ärzte Anton Fedorov und Julia Chibisova erhalten. Sie waren beide unglaublich und haben uns alles im Detail erklärt, als wir dort waren. Ich bin froh sagen zu können, dass Alex große Verbesserungen feststellt, die immer mehr zu werden scheinen. Wir können ihnen nicht genug danken. Wir sind einfach so dankbar. Wir werden definitiv wieder hinfahren und eine weitere Behandlung buchen, und wir können jedem, der sich in einer ähnlichen Lage befindet, nur empfehlen, die Fedorov Restore Vision Clinic zu kontaktieren.
Fedorov Restore Vision Clinic
Prenzlauer Allee 90
10409 Berlin (Germany)